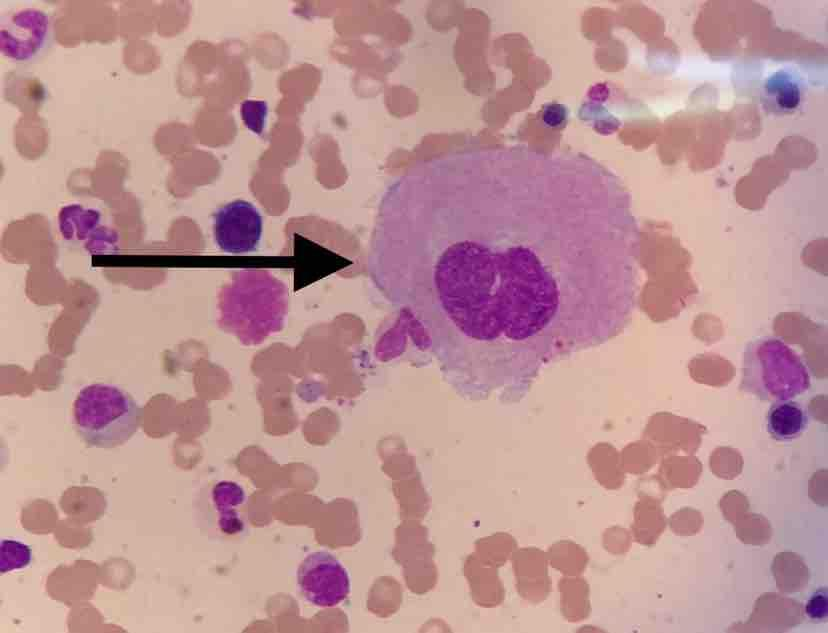

【第一百三十五期】基层检验网形态学培训
每周一次,每次几张,只要您坚持来,抽出几分钟的时间,相信您的识图能力会不知不觉的提升哦
1、箭头所示细胞为(骨髓,瑞氏染色 10×100):
答案:幼稚巨核细胞
解析:幼稚巨核细胞外形多为圆形或椭圆形,该细胞胞内可见两个核,核染色质粗糙,排列紧密,无核仁;细胞质较丰富呈灰蓝色,近核处含少许细小淡紫红色颗粒而呈淡红色,边缘有伪足样突起,附着较多血小板。
2、箭头所示细胞为(骨髓,瑞氏染色 10×100):
答案:颗粒型巨核细胞
解析:该细胞胞体巨大,核分两叶,核染色质粗糙呈条索状;细胞质丰富,胞内充满较多细小、大小一致的淡紫红色颗粒,未见血小板形成。
3、箭头所示细胞为(骨髓,瑞氏染色 10×100):
答案:双核(早)幼红细胞
解析:该细胞胞体圆形,边缘可见瘤状突起,胞内可见两个连着的核,核染色质较原始红细胞聚集,颗粒较粗,核仁隐约可见;胞浆深蓝色,核周淡染区明显。
4、箭头所示细胞为(骨髓,瑞氏染色 10×100):
答案:成骨细胞
解析:该类胞体较大,为长椭圆形或不规则形,成簇分布;胞核圆形或椭圆形,偏于一侧,呈粗网状,可见核仁;胞质丰富,灰蓝色,可见少许紫红色颗粒。
5、箭头所示细胞为(骨髓,瑞氏染色 10×100):
答案:破骨细胞
解析:该类胞体巨大,形态不规则,边缘不整齐,细胞核较多,彼此独立存在,呈粗网状;胞质丰富,呈灰紫色,胞质中含有大量细小及粗大紫红色颗粒。该细胞有血小板附着。
感谢:重医大附一院检验科和璧山区医学检验质量控制中心提供的内容。